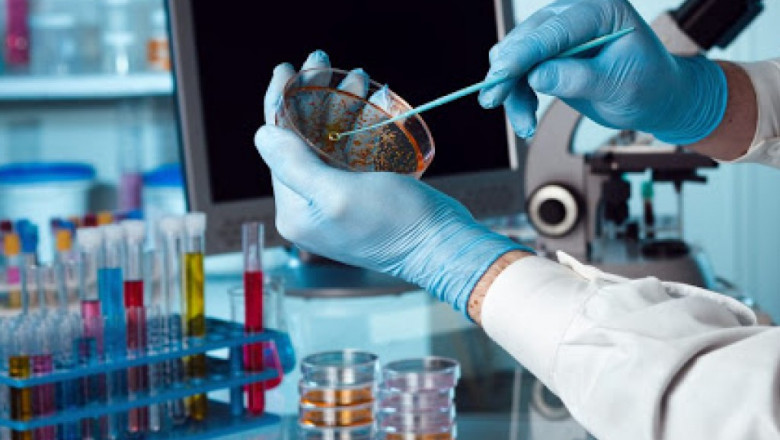
Enteric Disease Testing Market Dynamics

views
Rising enteric disease incidence and the cost-effectiveness of technologically advanced diagnostic systems are expected to drive demand for early enteric disease diagnosis. Salmonella bacteria, for example, cause approximately 1.35 million infections, 420 deaths, and approximately 26,500 hospitalizations in the United States each year, according to the CDC. Furthermore, a traditional diagnostic procedure, such as the culture method, required skilled personnel and was a time-consuming and tedious procedure. Over the last decade, the development of molecular diagnostics and other diagnostic technologies has revolutionised the enteric diseases testing market. As a result, rising demand for early diagnosis of these conditions is expected to propel the enteric disease testing market during the forecast period.
Read More:
https://knackersblogger.blogspot.com/2022/06/enteric-disease-testing-market-size.html